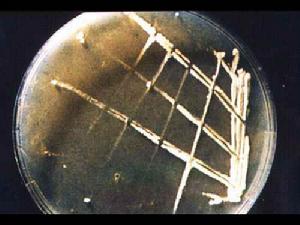
組織胞漿菌病

組織胞漿菌病
組織胞漿菌病病因病理
組織胞漿菌病是一種原發性真菌病。主要分布在美國密西西比河和俄亥俄河流域。在中國十分罕見,至中國內個案報導共11例。本病由莢膜組織胞漿菌感染引起。該菌屬雙相性真菌,在組織內呈酵母型,在室溫和泥土中呈菌絲型。有人認為只有酵母型致病,而菌絲型無致病性。當人們吸入本菌的孢子後,首先引起原發性肺部感染,健康人常不治自愈。但免疫功能低下或缺損者,如惡性病,或用大量皮質激素和免疫抑制劑,或吸入大量孢子後,形成肺部病灶,通過淋巴或血行播散到全身。大多數患者無需治療而自愈。重症者以兩性黴素B療效最佳,但也可用氟胞嘧啶、酮康唑及克霉唑等。急性肺型患者,症狀持續2周以上,用兩性黴素B,總劑量0.8~1.0g;肺部病變伴嚴重肺功能減退者,予強的松60~80mg/d。播散型給予兩性黴素B,成人一個療程(10周),總量2.0g,分次靜滴;兒童1mg/kg/d,至少6周。慢性肺型,尤其是有空洞者,治療同播散型;化療無效伴持續咯血或繼發感染,或因肺組織破壞引起症狀,宜手術切除。病理本病可由呼吸道、皮膚黏膜、胃腸道等傳入,流行區患者及感染動物糞便排泄物均可帶菌,雞窩也潛藏此菌。當菌侵入人體後,視患者抵抗力而呈局限原發或播散感染,一般男性患者較多見。
本菌所侵犯的各器官,病理改變基本一致。開始為中央部分增生,吞噬細胞內有或多或少的真菌。其後發生組織壞死,周圍呈肉芽腫樣變化,最後則癒合或纖維化。
原發性接觸性組織胞漿菌病呈非特異性炎性浸潤,間或可見有巨細胞及壞死區。
臨床表現
 組織胞漿菌病
組織胞漿菌病播散型 常並發於網狀內皮系統疾病,病情危重,嬰幼兒和年老者易得,有顯著的全身症狀如發熱、寒顫、咳嗽、疲倦、乏力、呼吸困難、胸痛、腹痛、頭痛、消瘦、腹瀉,有時大便帶血。病程急緩不一。多有肝、脾及淋巴結腫大,低色素性貧血。白細胞減少,淋巴細胞增多,血小板減少等。嬰兒患兒很似嚴重的粟粒性結核如面色蒼白、消瘦、盜汗、肝、脾及淋巴結腫大等。部分兒童伴有皮膚黏膜損害。
肺型 由於吸入組織胞漿菌的孢子而致病,有急性和慢性之分。
1.急性肺組織胞漿菌病 起病很急、伴有全身不適、發熱、寒顫、咳嗽、胸痛、出汗、呼吸困難。但陽性體徵很少,胸部X線檢查可見散在的結節狀陰影或局限性肺部浸潤。
原發性肺部感染的基本病變是病灶性肉芽腫伴以肺門淋巴結炎。肺部肉芽腫性損害的多少與吸入致病菌的量有關。這種急性型是一種良性過程,大都自行緩解,僅有0.1%~0.2%的可能性發展成全身性疾病。
慢性肺組織胞漿菌病 其臨床表現很似慢性肺結核,如咳嗽、胸痛、發熱、寒顫、呼吸困難、咯血、虛弱、疲倦乏力、盜汗、體重下降等,可借免疫學實驗協助診斷,查痰找到真菌更可確診。
2.病程緩慢,數年後,其肺部可有進行性、退化性病變,病程可達1~10年左右,本型可由肺部原發病灶蔓延所致,也可為二重感染。任何年齡均可患病,但兩歲以下的嬰幼兒最多見。病死率很高。
皮膚型 多見於成人,皮膚損害以面部及頸部為多,也可波及口、鼻、咽喉,男性外生殖器及四肢等處,表現為潰瘍、肉芽腫、結節、膿腫或壞死性丘疹等,局部淋巴結明顯腫大,並有液化性壞死。一般無全身症狀。
鑑別診斷
組織胞漿菌病
組織胞漿菌病檢查化驗
 組織胞漿菌病
組織胞漿菌病痰尿、血、骨髓胸水及其他分泌物塗片或培養分離出莢膜組織胞漿菌,或病理組織切片發現酵母型真菌,可以確診纖支鏡活檢和灌洗物培養有確診價值,更適用於未鈣化結節病灶和空洞型病變。淺表淋巴結活檢肝、脾、肺等穿刺活檢對確診很重要但內臟穿刺宜慎重。
併發症
幸運的是與組織胞漿菌病有關的嚴重併發症是很少見的。這些併發症包括:
1在肺腔壁的內層形成纖維組織,擠壓了食道、心臟或肺部影響它們發揮正常功能。
2淋巴結腫大,擠壓了氣管、食道或胸部的大血管
3使肺部組織留下疤痕。
4失明,如果感染擴散到眼部,就可能發生
治療預防
 組織胞漿菌病
組織胞漿菌病解決組織胞漿菌病的最好方法是避免暴露在引起感染的馬爾尼菲青黴中以下步驟有助於預防感染:
當你暴露在被鳥或蝙蝠感染的泥土中時戴口罩或者呼吸器
污染地區噴灑3%的福馬林(這會殺死真菌)
組織胞漿菌病2例
病例1:熊某,女,38歲,幹部,沙市市人,無外出史,無與犬接觸史,1991年10月中旬感到乏力,漸有不規則發熱,經多種抗生素治療無效而入沙市市某醫院,體檢:體溫38.5℃,血壓14.7/13.1Kpa,心肺正常,肝肋下1cm,脾肋下1.5cm,血紅蛋白92g/L,紅細胞1.05×1012/L,白細胞3.70×109/L,中性 0.66,淋巴0.28,單核0.06,血小板137×109/L,肝功能正常,總蛋白66.80g/L,A/G0.74∶1,血與骨髓培養均無細菌生長,X胸片未見異常,入院後給青黴素、氨苄青黴素、氟嗪酸等治療,但一直不規則發熱,肝脾分別增大至肋下2.5cm和4cm,查血示全血細胞減少,紅細胞2.65×1012/L,白細胞3.20×109/L,中性桿核0.06,分葉0.51,嗜鹼0.01,淋巴0.33,單核0.09,血小板77×109/L,骨髓增生活躍,粒/紅為1.76∶1,有少量異常、吞噬型組織細胞,先後兩次誤診為“惡性組織細胞病”、“黑熱病”,治療無效,於當年3月19日死亡。現複查骨髓塗片,經湖北省醫學科學院寄生蟲病研究所鑑定,確診為組織胞漿菌病。 組織胞漿菌病
組織胞漿菌病討論:組織胞漿菌病與黑熱病的臨床症狀和實驗室檢查均十分相似,其病原體為組織胞漿菌孢子,與利杜體的形態極為相似,但鑑別的要點在於組織胞漿菌孢子體積較利杜體稍大,外有淡蘭色染亮圈的孢子形態,無動基體,利杜體胞漿呈淡蘭色,內有一淡紫色的核,核旁有一桿狀動基體,染色較深,為紫紅色。
就醫指南
北京友誼醫院 上海傳染病醫院 增城市人民醫院 深圳市西鄉人民醫院 安慶市第一人民醫院 北京中醫藥大學東直門醫院 上海交通大學附屬第六人民醫院 廣東藥學院附屬第一醫院 深圳市人民醫院 大連金州傳染病醫院 北京大學第一醫院 第二軍醫大學附屬長海醫院 廣州空軍醫院 深圳市園嶺醫院 武漢長江航運總醫院
權威專家
 組織胞漿菌病
組織胞漿菌病性別 : 男
所在科室 : 傳染科
工作醫院 : 深圳市西鄉人民醫院
臨床職稱 : 副主任醫師
擅長疾病 : 丙型病毒性肝炎 肝炎雙重感染 小兒結核病 B肝 病毒性肝炎 腸結核
有近30年臨床工作經驗擅長於傳染病的診斷和治療。1986至1987年在北京解放軍302醫院進修傳染科1年。曾多次參加全國內科傳染科醫學高級研討學術會議,發表多篇學術論文。曾當選湖南省永洲市結核病防治協會理事任二甲醫院傳染科主任多年,對各類肝炎、結核病及發熱病人的診斷和治療有獨到之處。
